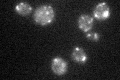
YGL203C

View description
Protease involved in the processing of killer toxin and alpha factor precursor; cleaves Lys and Arg residues from the C-terminus of peptides and proteins
Localization:
Intensity:
Fold change:
Significance:
-
C’ GFP library in SD

punctate49.15 -
N' NOP1pr-GFP in SD

N/A0 -
N' TEF2pr-mCherry in SD

N/A0 -
N' NATIVEpr-GFP in SD

N/A0 -
N' TEF2pr-VC and Cyto-VN in SD

N/A0 -
C’ GFP library in SD+DTT

punctate35.650.72No -
C’ GFP library in SD+H2O2

punctate39.810.8No -
C’ GFP library in Starvation Media
punctate42.10.85No -
C’ GFP library on the background of Pup2-DaMP

punctate -
C’ GFP library on the background of CCT mutant

punctate36.26890.737719No
